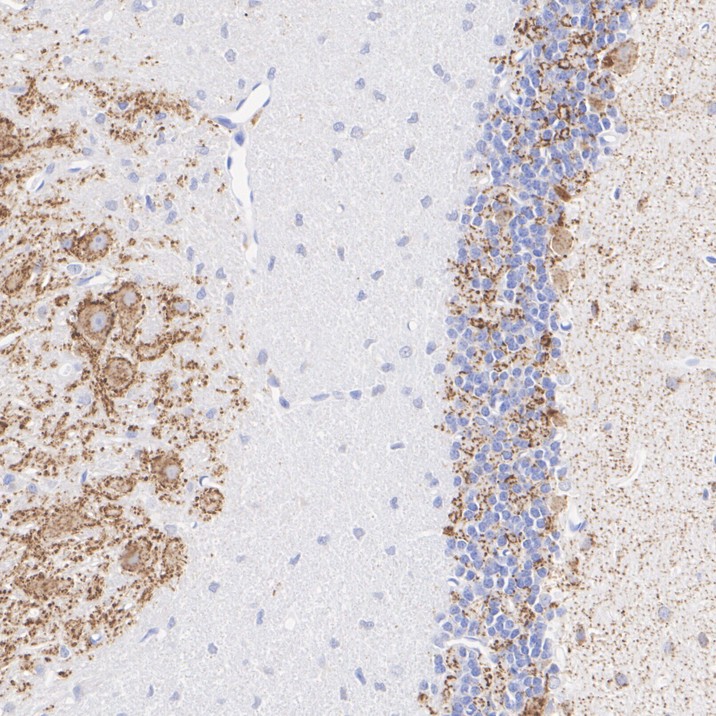

SLC32A1 / VGAT Recombinant Mouse Monoclonal Antibody [PSH10-47] - BSA and Azide free
Catalog# HA610228
SLC32A1 / VGAT Recombinant Mouse Monoclonal Antibody [PSH10-47] - BSA and Azide free
Application
-
IHC-Fr
-
IHC-P
Reactivity
-
Mouse
-
Rat
With BSA and Azide
-
HA601384
含抗保成分
Predicted reactivity
 Predicted species support after-sales service
Predicted species support after-sales service
-
Cynomolgus monkey
-
Pig
Conjugation
-
unconjugated